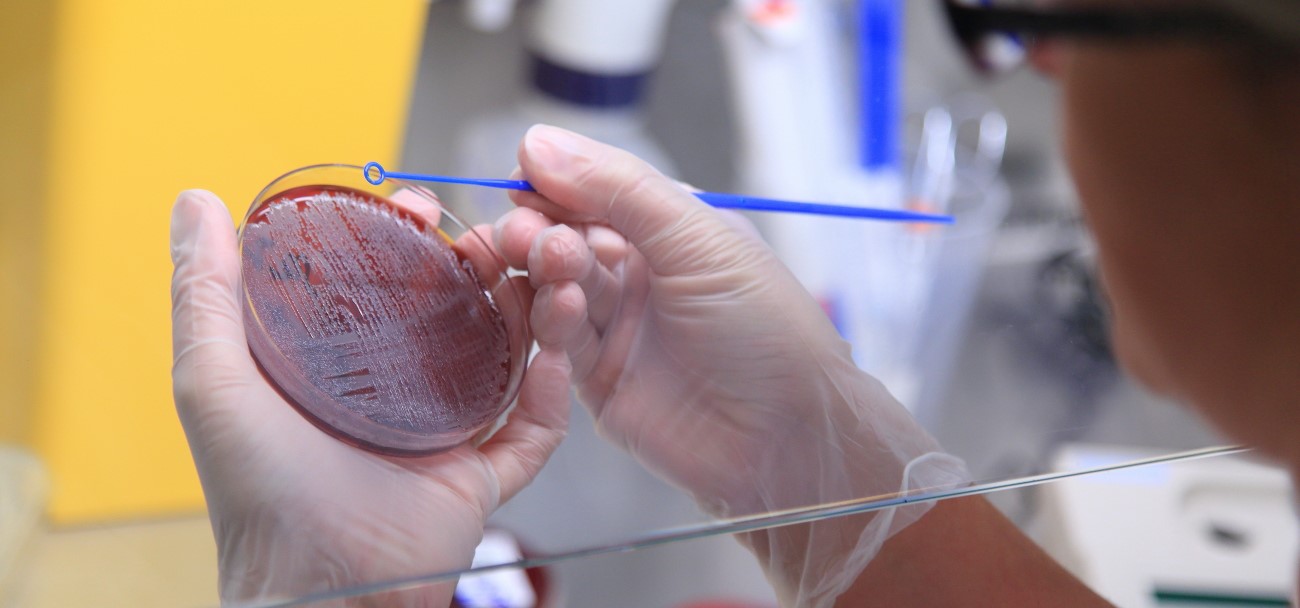

Laboratoire
Contacts
Le Laboratoire du CH Calais est ouvert à tous !
Pour vos analyses, après une consultation ou non, venez directement au laboratoire : le service vous accueille avec ou sans rdv.
Où trouver le service?
Le laboratoire se situe au niveau 0H, à côté des services administratifs, derrière la Direction des Soins.
Horaires:
Du lundi au vendredi :
07h30 – 13h00
13h30 – 16h
Avec ou sans rendez-vous.
Domaines du secteur technique :
- Biochimie – Immunologie – Sérologie,
- Hématologie – Hémostase,
- Immuno – Hématologie,
- Bactériologie – Parasitologie.
Mon test IST
Le Laboratoire du Centre Hospitalier de Calais propose désormais le dépistage des Infections Sexuellements Transmissibles.
Il est désormais possible de réaliser un dépistage IST au sein du Laboratoire du Centre Hospitalier de Calais telles que le VIH / Sida, l’hépatite B, la syphilis, la gonorrhée et la chlamydiose.
Ce dépistage est disponible sans RDV, sans ordonnance et gratuit pour les moins de 26 ans.
Plus d’infos : https://www.ameli.fr/assure/actualites/avec-mon-test-ist-le-depistage-des-ist-est-plus-facile-depuis-le-1er-septembre

Zoom sur : la chaîne BECKMAN DXA 5000 fit
Le laboratoire du Centre Hospitalier Técher de Calais est le premier établissement au monde où la chaîne BECKMAN DXA 5000 fit a été mise en production. Cette chaîne, plus compacte que les autres, permet une productivité élevée tout en ayant des dimensions plus adaptées aux laboratoires.
Les biologistes :
- Dr Salma BOURIGA, Chef de service
- Dr François ROSE, Responsable de la banque du sang
- Dr Sophie DELESALLE
- Dr David EL RASSI
- Dr Fabienne FLORCZAK
- Dr Hervé VERMEULEN
- Dr Lucile ETIENNE
C’est pratique !
- Dossier administratif géré au laboratoire
- Résultats directement transmis aux médecins de l’hôpital
- Plus besoin de vous déplacer : vos résultats sont disponibles directement sur Mon Espace Santé (sauf opposition de votre part)

Documents à présenter :
- Ordonnance du médecin
- Pièce d’identité (y compris pour les mineurs)
- Carte vitale
- Carte de mutuelle
